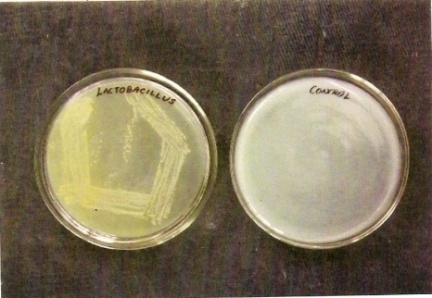

1Department of Microbiology, V. H. N. S. N, College, Virudhunagar – 626001. Tamil Nadu, India. 2Department of Chemistry and Biosciences, Srinivasa Ramanujan Centre, SASTRA University, Kumbakonam. Tamil Nadu, India. 3Department of Mathematics, Srinivasa Ramanujan Centre, SASTRA University, Kumbakonam. Tamil Nadu, India.
Email: microkannan@gmail.com
Received: 07 Nov 2014 Revised and Accepted: 03 Dec 2014
ABSTRACT
Objective: Nanotechnology is emerging as one of the most important and revolutionizing areas in the research field. Nanoparticles are produced by various methods like physical, chemical, mechanical and biological. Biological methods of microorganisms are often preferred because they are clean, non-toxic, safe, biocompatible and environmentally acceptable.
Methods: In the present studies isolation and characterization of Lactobacillus species (LAB) from Curd was done with MRS agar (Hi Media, India. M614). All the isolates were subjected to cell morphology, physiology and an array of biochemical characterization (BCT). The confirmed LAB was used for the TiO2 nanoparticles synthesis. The TiO2 nanoparticles were then characterized by Fourier Transform Infra-Red Spectroscopy (FTIR), Scanning Electron Microscope (SEM).
Results: The SEM images of samples revealed that the nanoparticles were spherical, irregularly shaped with no definite morphology. Biosynthesized TiO2 nanoparticles were ranged in size from 20 to 50 nm.
Conclusion: The presence of TiO2 nanoparticle was confirmed by face centered cubic structure of synthesized TiO2 nanoparticle was confirmed by FTIR pattern.
Keywords: TiO2 nanoparticle, Lactobacillus, Decolourisation of dyes.
INTRODUCTION
Nanosized particles have engrossed international attention in recent days due to their extraordinary optical, chemical, photo electrochemical and electronic properties. These particles have many applications in a broad range of areas. It seems that nanoscience might take vital role in various key future technologies since recent efforts in fabricating these nanosized structures into predefined superstructures. In order to meet the wide scope of nano material’s, an awe-inspiring number of protocols have been exploited for their synthesis, but regrettably, most of them are capital-intensive, incompetent in material and energy use, and often pose health hazards as a consequence of usage of toxic chemicals [1]. Therefore, it is a necessary to develop safe, reliable, nontoxic, gainful, clean, and ecofriendly methods for preparing nanoparticles. As a result, nanomaterial separation mediated by biological systems (bacteria, fungi, and plant extracts). Both intracellular and extracellular construction of nanoparticles from non-living materials is a famous attribute of several microorganisms [2]. Nanoparticles of a wide range of materials can be prepared by a variety of methods. Three main methods of synthesis techniques have been developed: chemical synthesis, Physical synthesis and biological synthesis.
Most properly unicellular organisms such as magneto tactic bacteria produce magnetite nanoparticles, and in the same way, diatoms synthesize siliceous materials. Although microorganisms like bacteria and fungi have been engaged in the remediation of toxic metals, their exploitation as possible ecofriendly nano factories has occurred recently [2]. Nanoparticle bioconjugation have been reported by several researchers in recent years, including synthesis of TiO2 nanoparticles straight synthesis [3, 4, 5, 6, 7, 8, 9, 10, 11, 12, 13, 14 & 15] but very limited works deals with the biosynthesis of TiO2 nanoparticles by LAB isolated from curd samples. The unique optical and electronic properties of TiO2 nanoparticles make them model candidates for cell targeting and also as efficient tools for bioassays. Here we are reported that isolation and characterization of Lactobacillus (LAB) species from Curd sample.
The LAB was used for the intracellular synthesis of TiO2 nanoparticles. TiO2 has three crystal forms namely anatase, rutile and bookite. The well-organized photocatalytic activity of TiO2 deeply depends on its crystallite size, surface area, and crystal structure [16]. A curiosity, environmental compulsion and understanding that nature has evolved the processes for synthesis of inorganic materials on nano and micro length scale have created the great interest for done this research work. It illustrates that the removal efficiencies of methyl orange by biosynthesized nanoparticles. The UV-Vis spectra of methyl orange solutions were analyzed for decolorization studies by TiO2 nanoparticles.
MATERIALS AND METHODS
The employment of microorganisms such as bacteria in the nanoparticles production is a modern trend. The microorganisms diminish the toxicity by reducing the metals or by creating insoluble complexes by means of metal ion in the form of colloidal particles. A curiosity, environmental pressure and accepting that nature has evolved the processes for the synthesis of inorganic materials have created greater interest for done this research work.
Isolation of Lactobacillus sp. from curd
Curd sample 1 ml was suspended in 9 ml sterile distilled water. The diluted 0.1 ml of curd sample was spread plated on the Mann Rogosa Sharpe (MRS) agar (100 ml) composed of glucose (2g), peptone (1g), sodium acetate (1.5g), beef extract (1g), yeast extract (1.2g), ammonium citrate (0.2g), Na2HPO4 (0.2g) and incubated for 24 hours at 37°C. The individual bacterial colonies were isolated and maintained on MRS slant and used for further studies.
Identification of Lactobacillus sp.
Lactobacillus sp. was identified by the Bergy’s manual, based on the morphological (Pigments, motility, Gram staining) and biochemical characteristics (Indole, Methyl red, Voges praskauer, Catalase, Urease, Triple sugar iron agar test).
Synthesis of TiO2 Nanoparticles using Lactobacillus sp. of curd
Titania nanoparticles were synthesized using the method [17] with small changes. The filtrate was diluted 5 times. pH of the culture solution was maintained as 2–4 depending on the strength of the solution. Then 10% lactose solution was added to the culture solution and incubated overnight. 20 ml 0.025 (M) titanium dioxide solution and 10-3 M Potassium silico fluoride was added next morning. Culture solution has now been mixed systematically on a magnetic stirrer for 0.5 h and incubated in laminar flow. In control experiments, the bacterial biomass was resuspended in double distilled water in the absence of aqueous solution and the filtrate obtained thereafter was used for further characterization.
Ultraviolet-visible and fluorescence spectroscopy
The biosynthesized TiO2 nanoparticles, were characterized using Shimadzu UV-160 (Japan, Kyoto) spectrophotometer. The process was monitored at every 12 hrs up to 48 hrs for each 24 hrs up to 96 hrs for Lactobacillus sp. The emission spectra from 250 nm to 285 nm and excitation at 257 nm were collected. The emission and excitation slits were set at 4.2 nm.
Fourier transforms infrared spectroscopy
Fourier transform infrared spectroscopic measurement of the TiO2 nanoparticles was performed by Perkin-Elmer infrared spectrophotometer with a resolution of 4 cm-1, in the range of 400–4000 cm-1.
SEM analysis of biosynthesized TiO2Nanoparticles
SEM method was used to study the surface morphology of the titania nanoparticles. The SEM micrograph showed the control of metal oxide nanoparticles aggregates in the range between 20 and 50 nm. The nanoparticles were not in direct contact even within the aggregates, indicating stabilization by a protein capping agent.
Potential in detection of decolourization of methyl orange dyes
Dye solutions were prepared using double distilled water at 50 mgL-1of Methyl orange. The 50 ml of dye solution was taken in 100 ml Erlenmeyer flask and 0.25% and 0.5% (W/V) of biosynthesized titania nanoparticle was added and then stirred the flask at 150 rpm by shaker up to 300 min. The whole experiment was done at room temperature. At 60,120,180,240 and 300 minutes samples were collected and centrifuged for 5 minutes at 6,000 rpm. The residual concentrations of dye were estimated by UV-Vis spectrophotometer at 461 nm for methyl orange. Methyl orange before and after treatment with silica and titania nanoparticles were also studied by observing the change of UV-vis spectrum. To examine the consequence of pH on decolorization of methyl orange by biosynthesized nanoparticles, the pH of the dye solution was adjusted to 3,5,7,9 using 1.0M HCl and 1.0M NaOH before treatment by nanoparticles.
RESULTS
Characterization of the isolates
The morphological and biochemical characteristics of the isolates were investigated. The isolates were identified based on the following parameters: the pigments, motility, Gram staining and Growth on Solid MRS Medium, Growth on Liquid MRS Medium. As per the Bergey’s manual of determination bacteriology, the organism was conformed as Lactobacillus sp. The plates showed a round, smooth white colored colonies and they were gram positive, rod shaped when observed microscopically. table 1 shows the characteristics of Lactobacillus sp. and fig. 1 indicates the Lactobacillus sp. on MRS agar and fig. 2 indicates the light microscope view of Gram positive rod at 40X magnification.
Biomimetic synthesis of TiO2nanoparticles of Lactobacillus sp. from curd sample
In silica nanoparticle biosynthesis, the flask with isolated culture biomass was pale yellow colour, but the flask containing potassium silico fluoride and biomass was colourless on completion of the reaction.
After 96 hours of incubation period, the titania nanoparticle was observed in the flask containing isolated culture with titanium dioxide. The deposits were observed at the bottom of the conical flask and the initial pH 3 was changed in 6-7. In control flask, there was no deposition and a pH change was observed.
Table 1: Morphological characterization of lactobacillus sp.
| S. No. | Biochemical Characteristics | Observation | Morphological Characteristics | Observation |
| 1. | Indole Test | + | Pigments | White colour |
| 2. | MR Test | - | Motility | Non-motile |
| 3. | VP Test | + | Gram stain | Gram positive, rod |
| 4. | Catalase Test | - | Growth on solid MRS | Circular and smooth |
| 5. | Urease Test | + | Growth on liquid MRS | Uniform turbidity with Sediment |
| 6. | Triple Suger Iron agar | Acid formation |
Fig. 1: Lactobacillus sp. on MRS agar

Fig. 2: The light microscope view of Gram positive Rod at 40X magnifications

Fig. 3: TiO2 Nanoparticles synthesized from Isolated Lactobacillus sp. from Curd
Characterization of biosynthesized nanoparticles by UV-Vis spectroscopy
The UV-Vis spectra were recorded from the aqueous potassium silico fluoride- and titanium dioxide for Lactobacillus sp. reaction medium as a function of time. Titania surface plasmon band occurs at 257 nm. Gradually increases the intensity as a function of the time of reaction complete oxidation of the titanium dioxide by Lactobacillus sp., occurs after nearly 96 hours of reaction (fig. 4).

Fig. 4: Uv-Vis spectra for titania nanoparticles obtained by Lactobacillus sp. As a function of reaction time
Characterization of biosynthesized nanoparticles by Fourier transform infrared spectroscopy
FTIR spectroscopy dimensions were carried out to recognize the biomolecules and capping reagents in the Lactobacillus sp that were responsible for the reduction of chloroaurate ions and the constancy of the bioreduced nanoparticles, respectively.
11Curves displays the FTIR spectrum of the TiO2 Nanoparticles and shows, bands in the regions from 3984.27 to 669.58 cm (fig. 5). It illustrates more peaks at 3984.27 60.33 3771.92 60.11 3398.19 41.84 2924.23 52.79 2362.44 52.63 2344.99 53.98 1637.13 55.36 1439.66 57.13 1052.84 35.25 896.05 60.74 669.58 10.45.
Characterization of biosynthesized nanoparticles by SEM analysis
The surface morphology of the silica and titania nanoparticles were studied by Scanning electron microscopy method. The size of nanoparticles aggregates (fig. 6) in the range between 20 and 50 nm.

Fig. 5: FTIR analysis of titania nanoparticles by Lactobacillus sp

Fig. 6: SEM Micrograph of biosynthesized titania nanoparticles by Lactobacillus sp
Potential in detection of decolourization of methyl orange dyes by bacterial-mediated biological TiO2 Nanoparticles
Fig. 7 illustrates the removal efficiencies of methyl orange by biosynthesized nanoparticles. The UV-Vis spectra of dye methyl orange solutions before and after decolorization by titania nanoparticles is shown in fig. 8.
Titania nanoparticles (TiNp) were much faster than titanium dioxide (TiO2) in decolorization under the same experimental conditions.

C-Control T-Time of reaction in minutes (180,240,300)
Fig. 7: Decolourization of methyl orange dye by biosynthesized nanoparticles

Tio2 – Titanium dioxide, TiNP – Titanium Nanoparticle
Fig. 8: UV spectra showing decolourization ability of biosynthesized nanoparticles.
From the results it was shown that lowering pH from 5,6,7,8 increased the removal kinetic rates. At pH 5, the decolourization of methyl range using titania nanoparticles were reached 75% after 360 minutes treatment (fig. 9). As an outcome, the pH would strongly affect the degradation of methyl orange by titania nanoparticles.

Fig. 9: The effect of pH on dye decolourization by titania nanoparticles
DISCUSSION
The synthesis of nanoparticles using microbes is a quite new research area owing to its low cost, nontoxicity, high reproducibility, and an easy attainment at ambient temperatures and pressure and it has been proved success [19, 20 & 21]. Biogenic (Bacterial – Mediated) synthesis of nanoparticles, was found to be economically viable, simple and environment friendly [7,18–23]. Magnetic nanoparticles coated with metal oxides, such as zirconium oxide, titanium oxide and aluminium oxide are having effectual attraction probes for phosphorylated species, which bind to the metal oxide surfaces through monodentate, bidentate and tridentate relations of the phosphate units to the metal ion centres [23].
The nanoparticles were primarily characterized by UV–Visible spectroscopy, which has proved to be a very helpful technique for the investigation of nanoparticles. The bio-transformation was usually monitored by visual examination of the biomass as well as measurement of the UV-vis spectra from the fungal cells. The optical absorbtion spectra of metal nanoparticles are conquered by surface Plasmon resonances (SPR), which shift to longer wavelength with increasing particle size [24].
In our studies FTIR analysis showed the presence of a resonance at ca. 600 cm-1-1100 cm-1 that are these peaks correspond to exitation of Ti-O-Ti vibrational mode in the particles. A band at 834.67 cm-1 weak corresponds to exitation of the Ti-O antisymmetric stretching of Ti-O-Ti bonds. The absorption bands at ca.1540.39 cm-1indicated by the amide band in the particle, these bands were missing in the titanium dioxide. This indicates the presence of protein in the titania nanoparticles. Previous work reported that the C=C stretching mode, C-H stretching mode, CH2 asymmetric stretching mode and symmetric stretching occurs at the standard wave numbers respectively [13].
Analysis of the TiO2 nanoparticles showed size of 20 – 50 nm which is similar to previous studies. In the case of Verticillium sp. reduction of the metal ions happened intracellularly which leads to the development of gold and silver nanoparticles.
Dyeing industry waste water is characterized by high concentration, complicated component, deep colour, and difficult to biodegrade. Treatment of wastewater by chemical coagulation and biological methods to lessen chemical oxygen demand (COD), biological oxygen demand (BOD) and suspended solids are in general agreeable, except for the removal of dye colour [14–16,19,24]. Therefore, the decolorizing treatment of dye wastewater is a difficult problem to solve. Many researchers have studied on the semiconductor nanoparticles as a photocatalyst in decolorization of dye wastewater [6]. Among a range of photo catalysts, titanium dioxide (TiO2) is the most preferable due to its insoluble, non-toxic, high photoactivity, stability and economical nature [25]. The UV-Vis spectra of dye methyl orange solutions before and after decolorization by silica and titania nanoparticles may resulted from the elevated surface area of nanoparticles, which offer more surface active sites for collision with dye molecules to speed up the dye removal efficiencies. The decrease in the absorbance indicates that chromophore group, the basic functional group of dyes for its colour was broken down [26].
CONCLUSION
Improvement in nanotechnology is probably having a great socioeconomic impact in basically all industrial sectors, particularly in dye degradation, with precise application in lower rate and more valuable. At present, there is a crucial require to extend biosynthetic procedures for nanoparticle as a substitute to toxic, eco-hazardous and elevated cost synthetic methods. We reported here biogenic (Bacterial – Mediated) synthesis of TiO2 nanoparticles, which was created to be economically viable, simple and Eco- friendly. It was also conformed that a higher concentration of bacterial mediated biological source favored the formation of spherical nanoparticles which are efficient in dye removal.
CONFLICT OF INTEREST
The authors declare that there is no conflict of interests regarding the publication of this paper.
REFERENCES